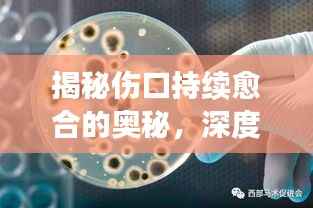

在日常生活中,我们不可避免地会遇到各种意外伤害,导致身体出现伤口,伤口的愈合是一个复杂的过程,涉及到许多生物学和医学领域的知识,本文将探讨如何促进伤口不断愈合,帮助患者更快恢复健康。
了解伤口愈合的基本过程
伤口愈合是一个涉及炎症、细胞增殖和基质重塑的复杂生物学过程,当身体受到损伤时,伤口处的血液凝固,白细胞聚集以抵抗感染,随后成纤维细胞和内皮细胞开始增殖,形成新的组织和血管,伤口逐渐缩小,直至完全愈合。
促进伤口愈合的关键因素
1、适当的营养摄入:营养是伤口愈合的关键因素,特别是蛋白质、维生素和矿物质等营养素,对伤口愈合具有重要作用,患者应在伤口愈合期间保持均衡饮食,摄入足够的营养。
2、保持良好的血液循环:血液循环为伤口提供充足的氧气和营养物质,有助于伤口愈合,患者可以通过适当运动、按摩等方式改善局部血液循环。
3、伤口护理:正确的伤口护理是伤口愈合的关键,患者应保持伤口清洁干燥,避免感染,定期更换敷料,以促进伤口的愈合。
4、药物治疗:一些药物如抗生素、生长因子等可以加速伤口愈合,患者应在医生指导下合理使用药物。
如何促进伤口不断愈合
1、选择合适的伤口敷料:根据伤口的类型和严重程度,选择合适的伤口敷料,湿性敷料有助于保持伤口湿润,促进细胞增殖;生物敷料可提供生物活性物质,加速伤口愈合。
2、物理治疗:通过物理治疗方法,如超声波、激光等,可以促进伤口愈合,这些方法可以加速局部血液循环,促进炎症消退和细胞增殖。
3、免疫调节:免疫系统在伤口愈合过程中起着重要作用,通过调节免疫功能,可以促进伤口的愈合,适当使用免疫调节药物可以增强机体的抗炎和抗氧化能力,有助于伤口愈合。
4、中医治疗:中医在伤口愈合方面有着独特的优势,中药外敷、针灸等方法可以活血化瘀、促进气血流通,有助于伤口愈合。
注意事项
1、避免过度活动:过度活动可能导致伤口裂开或加重炎症,影响伤口愈合,患者应在伤口愈合期间适当休息,避免剧烈运动。
2、定期复诊:患者应在伤口愈合期间定期到医院复诊,以便医生了解伤口愈合情况,及时调整治疗方案。
3、遵循医生建议:患者应在医生的指导下进行治疗和护理,不要随意更改治疗方案或自行使用药物。
伤口愈合是一个复杂的过程,需要患者和医生共同努力,通过了解伤口愈合的基本过程、促进愈合的关键因素以及促进伤口不断愈合的方法,我们可以帮助患者更快恢复健康,注意事项的遵守也是确保伤口愈合顺利的重要方面。
转载请注明来自东莞市霖钢包装机械设备有限公司,本文标题:《揭秘伤口持续愈合的奥秘,深度研究与探讨》

粤ICP备2020133062号-1
还没有评论,来说两句吧...